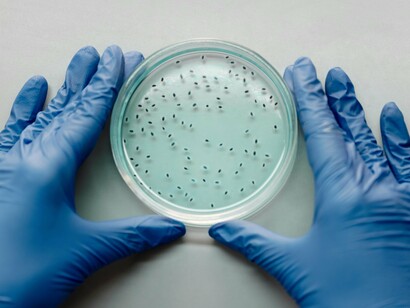
Petri dishes filled with thriving microbes, reflecting the complex world of the gut microbiome
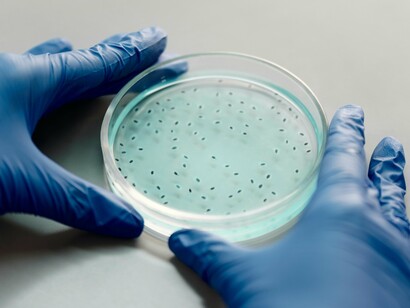
Petri dish layered with bacterial colonies, representing the hidden influencer of our mental and physical states

We have all experienced that feeling at one time or another—a "gut-wrenching" disappointment, butterflies before a big presentation, or a “nervous stomach” during stressful moments. We have made use of these phrases for hundreds of years without really understanding them. What if these statements were not merely figures of speech? What if your digestive system is literally having a chat with your brain and, in the process, influencing your emotions, your decisions, and your mental resilience?
Welcome to the fascinating world of the gut-brain axis, where the trillions of microbes that live inside your intestines play an important role in your mental well-being. This is not science fiction; it’s one of the most exciting areas of today’s medical research.
Beyond digestion: meet the 100 trillion roommates shaping your mind
Most times, we imagine that our gut is nothing but a simple food processing plant. However, our gut is much more than this. It is where our microbiome resides. The microbiome is a huge community of viruses, bacteria, and fungi whose numbers are far more than our own human cells.
This colony of microbiomes is not passive. Try to imagine it as an internal organ that is very active and which:
Produces important vitamins
Assists in training your immune system
And, most surprisingly, communicates directly with your brain.
These roommates are microscopic. They are also silent partners in your everyday life. They have more influence over you than you can imagine.
The gut-brain axis: your body’s superhighway of signals
At this point, the question we need an answer to is how does the bacterium in our colon communicate with our brain? This communication is made possible through many sophisticated channels:
Inflammatory Signals: If your gut is unhappy, then it is likely that a body-wide inflammation can be triggered. Such inflammations have strong links to mood disorders.
Neurotransmitters: The microbes inside your gut produce around 90% of the serotonin in your body as well as other molecules that influence our moods. Serotonin is a chemical that makes us "feel good."
The Vagus Nerve: This is the information superhighway of our bodies. It consists of a long cranial nerve that runs from our brainstem to our abdomen; in the process, it transmits signals in both directions.
As you can imagine, this is a continuous two-way conversation that has a tremendous effect on everything from your sleep quality to your response to stress.
The anxiety microbe: can bacteria really make you stressed?
From the conclusions drawn from recent ground breaking research, the answer could be yes. Scientists removed bacteria from the guts of humans with anxiety and had them transplanted into mice. The result? The mice began displaying anxious behaviours.
In a similar vein, scientific studies in human beings have discovered that people with particular psychological conditions usually have uniquely different gut microbiomes compared to those without them. This does not mean that anxiety is only caused by bacteria. However, it appears that bacteria might be a major player in a complex orchestra of factors.
Psychobiotics: the future of mental health treatment?
The ongoing research into gut health and microbes has led to the rise of a new field of study known as psychobiotics. Psychobiotics are living organisms that provide a mental health benefit as long as they are ingested in adequate amounts.
Although this field of scientific study is still young, early research on particular strains such as Bifidobacterium longum and Lactobacillus helveticus has revealed promising results in the improvement of moods and reduction of stress.
It is not just about consuming any yoghurt in order to build these beneficial bacteria; it's really about applications that are backed by research, targeted, and still being investigated.
Feed your bugs: the diet that nurtures a calm mind
So, if we are not expected to consume more yogurt, how are we supposed to cultivate these essential microbiomes that support mental wellness? It is simply by feeding it well. These vital bacteria that we all desire to encourage and build up in our guts flourish when we consume particular foods.
In order to provide nourishment for a healthy gut, eat more of the following:
Polyphenols: Olive oil, green tea, and dark chocolate
Fermented Foods: Kimchi, kefir, yogurt, and sauerkraut (source of live bacteria)
Fibre-Rich Foods: Nuts, oats, legumes, and berries (food for good bacteria).
Try to limit artificial sweeteners and ultra-processed foods. They can harm beneficial microbes.
Beyond food: how sleep, stress, and environment reshape your inner ecosystem
Everything is not solely dependent on what we eat. The dream we have of a perfect and well-functioning body goes beyond the food we consume every day. Our whole lifestyle has a tremendous influence over the garden in our guts. In order to achieve the best health for our guts, we need to eradicate or reduce to the barest minimum the following:
Poor Sleep: When we don't have enough sleep, it tends to disrupt the circadian rhythm of the bacteria in our guts.
Over-Sanitization: Making use of too many antibiotics and antibacterial products can wipe out both the good and bad bacteria.
Chronic Stress: When we are severely stressed out, it tends to reduce microbial diversity.
In order to promote the optimum functioning of our guts, we should adopt a holistic approach to our overall health and fitness. This means that making sleep a priority, effectively managing stress, and deliberately spending time in nature are all as essential as eating a diet that is rich and balanced.
From hype to hope: separating microbiome science from science fiction
It is essential that we approach this interesting field with an open mind, a balanced perspective, and cautious optimism. What we are witnessing right now is the start of a new revolution in science, not the end of it.
This is the reason why we should all beware of:
Extreme diets that claim to have the ability to "reset" your gut in a matter of hours or days.
Supplements or products that promise you instant or miraculous cures.
Remember that the true science is more nuanced and lays emphasis on habits that are long-term and sustainable. True science does not emphasize quick fixes like those questionable products.
Conclusion: listening to the whisper
It can be both empowering and humbling to realise that our mental state is influenced by something that seems unrelated and inconsequential as gut bacteria. What this idea should remind us is that our bodies are systems that are deeply interconnected, not a collection of separate parts.
Even though we should not throw away traditional approaches to mental health, this research provides a new layer of insight and understanding, as well as a new set of tools. When we take care of our gut through good sleep, stress management, and mindful eating, it is very likely that we are going to be nurturing and building a mind that is more resilient and calmer.
So, when next you think that you are having a "gut feeling," it probably would be worth taking some time out to consciously and closely listen. It probably might be that your microbiome is trying to communicate with you.